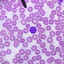
x auf Polnisch

Moja lekcja
0 1 Datenblatt jmvvz5dqfq
mp3 downloaden
Drucken
spielen überprüfen
Perfekt für Zuhörer – verwandeln Sie Ihre Worte in Audiocurs und lernen Sie:
wenn Sie mit dem Bus oder dem Auto fahren
mit einem Hund spazieren gehen
Warten in der Warteschlange
vor dem Zubettgehen
Diese Funktion ist nur für Premium-Benutzer verfügbar.
aktiviere das Premiumkonto Beispielaufnahme
wenn Sie mit dem Bus oder dem Auto fahren
mit einem Hund spazieren gehen
Warten in der Warteschlange
vor dem Zubettgehen
Diese Funktion ist nur für Premium-Benutzer verfügbar.
aktiviere das Premiumkonto Beispielaufnahme
Perfekt außerhalb des Hauses – drucke deine Worte:
als praktische Liste
als Teile geschnitten werden
Diese Funktion ist nur für Premium-Benutzer verfügbar.
aktiviere das Premiumkonto Musterausdruck
als praktische Liste
als Teile geschnitten werden
Diese Funktion ist nur für Premium-Benutzer verfügbar.
aktiviere das Premiumkonto Musterausdruck
Frage  |
Antworten  |
|||
|---|---|---|---|---|
| Lernen beginnen | |
|||
Sie müssen eingeloggt sein, um einen Kommentar zu schreiben.

Fehler melden
Danke für den Hinweis :)
Gut gemacht, gut Sie gehen :)
Der Schöpfer ist die Flashkarte Jmvvz5dqfqPunkt Klicken Sie auf Ihre eigenen Lernkarten erstellen :)
Wenn Sie bereit bevorzugen, versuchen Sie unsere professionelle Kurse.
Wenn Sie bereit bevorzugen, versuchen Sie unsere professionelle Kurse.
Wiederholen Sie alle
Wiederholen schwieriger
Ende der Runde 1
Summe
| Runde | I | Ich weiß nicht, |
|---|---|---|
| 1 | () | () |
Nächste Runde
Wiederholen Sie, was Sie nicht wissen,
- Deutsch
- English
- American English
- Français
- italiano
- Nederlands, Vlaams
- Norsk
- język polski
- português
- русский язык
- Svenska
- español
- українська мова
- gjuha shqipe
- العربية
- euskara
- беларуская мова
- български език
- 中文, 汉语, 漢語
- dansk
- Esperanto
- eesti keel
- føroyskt
- suomen kieli
- galego
- Gàidhlig
- ქართული
- ελληνικά
- עברית
- हिन्दी, हिंदी
- Bahasa Indonesia
- Íslenska
- 日本語, にほんご
- ייִדיש
- ಕನ್ನಡ
- Қазақша
- català, valencià
- 한국어, 韓國語, 조선어, 朝鮮語
- hrvatski jezik
- latine
- latviešu valoda
- lietuvių kalba
- Lëtzebuergesch
- bahasa Melayu, بهاس ملايو
- Malti
- македонски јазик
- Papiamento
- فارسی
- Português brasileiro
- rumantsch grischun
- limba română
- српски језик
- slovenský jazyk
- slovenski jezik
- ไทย
- český jazyk
- Xitsonga
- Setswana
- Türkçe
- magyar
- اردو
- Tiếng Việt
- isiXhosa
- isiZulu
Wählen Sie die richtige Antwort
Entdecken Sie alle Paare in der kleinsten Anzahl von Zügen!
0 Treppe
Neues Spiel:


